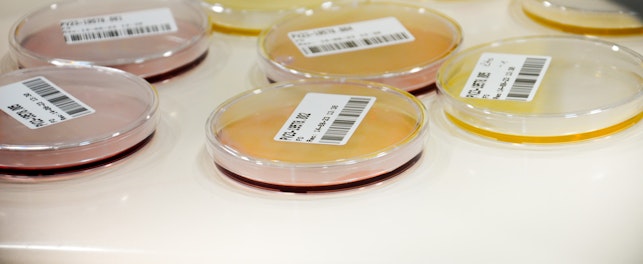
Muestras laboratorio HN puerto varas chile

La industria alimentaria abarca diversas áreas críticas que deben ser analizadas para garantizar la inocuidad y seguridad de los alimentos que consumimos. Uno de estos aspectos clave es el control de los Materiales en Contacto con Alimentos (MCA), presentes en todas las etapas de la cadena alimentaria: producción, procesamiento, almacenamiento, preparación y servicios previos al consumo final. Esto significa que elementos como envases, utensilios y maquinarias utilizados durante el proceso tienen el potencial de transferir sustancias no deseadas a los alimentos, lo que podría comprometer la salud de los consumidores si no se gestionan adecuadamente.
Los MCA se refieren a cualquier material o artículo que entra en contacto directo o indirecto con alimentos, lo que pueden incluir:
- Envases de plástico, vidrio, metal o cartón.
- Utensilios de cocina, vajillas y equipos.
- Tintas, etiquetas o adhesivos utilizados en el envasado.
- Y otros
Al interactuar con los alimentos, componentes químicos de estos materiales pueden migrar, generando riesgos a la salud. Asegurar la inocuidad alimentaria es una prioridad para empresas y autoridades en Chile y el mundo.
Actualmente, la fiscalización y cumplimiento de los estándares internacionales de calidad e inocuidad de los Materiales en Contacto con Alimentos (MCA) en Chile se encuentran regulados por el D.S. N°977, que aprueba el reglamento sanitario de los alimentos, abordando en sus artículos 122 al 129 la correcta composición y utilización de los objetos que entrarán en contacto con los alimentos, delimitando sus usos y condiciones para evitar la contaminación de monómeros residuales, metales pesados o cualquier contaminante indeseado que pueda liberar sustancias tóxicas. Además, se menciona los requisitos específicos para el uso de envases de retorno, subrayando la importancia de una adecuada higienización antes de ser reutilizados, a fin de garantizar la inocuidad.
Cuando los Materiales en Contacto con Alimentos (MCA) no son evaluados ni certificados adecuadamente, pueden transferir compuestos peligrosos, comprometiendo la salud de los consumidores. Pero, ¿qué factores determinan el riesgo potencial de estos materiales?
- Tipo de alimento con el cual estará en contacto
- Condiciones de uso, como temperatura, tiempo de exposición y tipo de almacenamiento.
- Vida útil del producto y/o material
- Limpieza e higienización adecuada del material
- Condición de reciclabilidad del material
Uno de los principales focos de preocupación es el uso de materias primas reguladas y autorizadas, así como el cuidado en los procesos de fabricación para evitar cualquier tipo de contaminación. Este aspecto es fundamental, ya que los alimentos podrían verse afectados por:
- Productos plásticos, que pueden liberar compuestos químicos asociados a problemas endocrinos, infertilidad y cáncer.
- Vidrios coloreados, que tienen el potencial de liberar metales pesados al entrar en contacto con ciertos líquidos.
- Teflón, que puede generar PFAS (sustancias perfluoroalquiladas y polifluoroalquiladas), relacionadas con el aumento del colesterol, daños en el desarrollo fetal y en niños lactantes, además de efectos negativos en el sistema inmune, el hígado y la tiroides.
En SGS, entendemos la complejidad y los desafíos que representa el manejo de MCA. Por ello, actuamos como un socio estratégico para nuestros clientes, ofreciendo servicios que permiten a las empresas garantizar que sus materiales sean seguros y cumplan con la normativa vigente a través de:
- Análisis y certificaciones para determinar que no existan contaminantes críticos que puedan transferirse a los alimentos, verificando el cumplimiento de las regulaciones nacionales e internacionales.
- Evaluaciones de seguridad para identificar y mitigar riesgos potenciales
- Revisión documental para garantizar que los materiales y procesos cumplen con los estándares exigidos
- Inspecciones que aseguran la conformidad en cada etapa de la cadena
- Auditorías especializadas que permiten verificar el cumplimiento integral de las normativas
- Capacitación y conocimiento, a través de seminarios, webinars y formaciones diseñadas para actualizar y preparar a los equipos en las mejores prácticas del sector.
Nos dedicamos a entregar soluciones confiables que ayudan a las empresas a cumplir con los más altos estándares de calidad, garantizando alimentos seguros y protegiendo la salud del consumidor final. Contáctanos aquí.
Acerca de SGS
SGS es la empresa líder mundial en pruebas, inspección y certificación. Operamos una red de más de 2,700 laboratorios e instalaciones comerciales en 119 países, respaldados por un equipo de 99,250 profesionales dedicados. Con más de 145 años de excelencia en el servicio, combinamos la precisión y exactitud que definen a las empresas suizas para ayudar a las organizaciones a alcanzar los más altos estándares de calidad, seguridad y cumplimiento.
Nuestro slogan – when you need to be sure – refleja nuestro compromiso con la confianza, la integridad y la sostenibilidad, permitiendo que las empresas prosperen con confianza. Nos enorgullece ofrecer nuestros servicios especializados bajo la marca SGS y a través de prestigiosas marcas asociadas como Brightsight, Bluesign, Maine Pointe y Nutrasource.
SGS cotiza públicamente en la Bolsa de Valores de Suiza (SIX Swiss Exchange) bajo el símbolo SGSN (ISIN CH0002497458, Reuters SGSN.S, Bloomberg SGSN:SW).